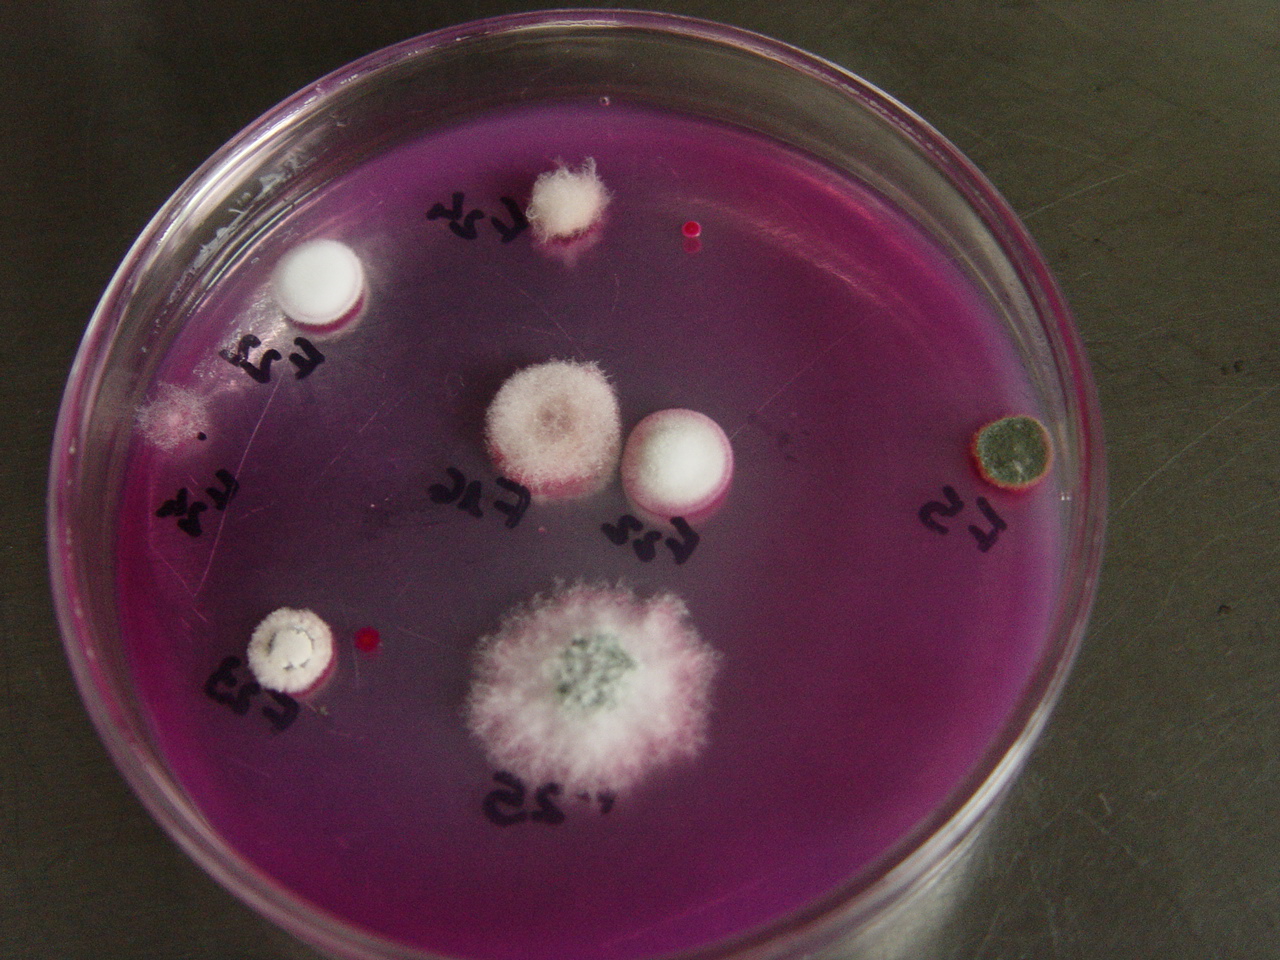

|
Laboratório de Biologia do Solo
|
|
O Laboratório de Biologia do Solo, pertence ao Departamento de Solos e Engenharia Agrícola/Setor de Ciências Agrárias da UFPR, com área construída de 75 m2. Tem como finalidades: dá suporte às aulas das Disciplinas AL 319 Biologia do Solo, ofertada para os cursos de Agronomia e Licenciatura em Biologia e AL 706 Biologia do Solo, ofertada para o curso de mestrado em Ciência do Solo; apoiar o desenvolvimento da disciplina AL 31 Introdução à Pesquisa em Solos, dissertações e teses. |
|
|
|
Práticas realizadas na rotina do Laboratório de Biologia do Solo |
|
|
|
Avaliação de microrganismos do solo |
|
|
|
Avaliação da mesofauna edáfica |
|
|
|
Avaliação de oligoquetas terrestres (minhocas) |